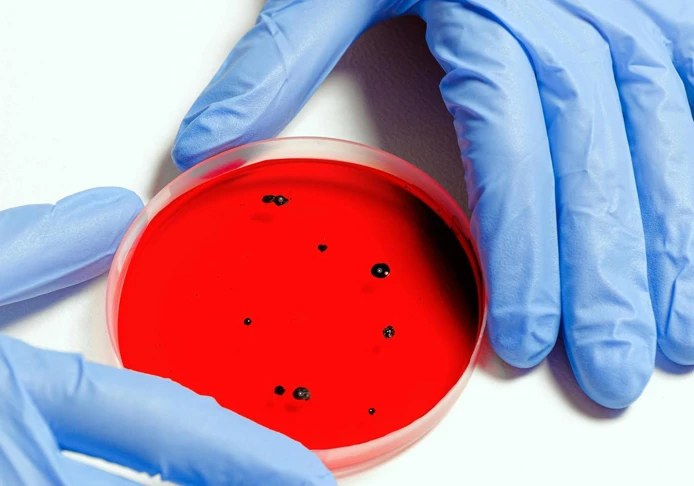
pexels-shvetsa-3786247.jpg.

-
Produktsortiment
- Extra mjuka torkdukar
- Extra slitstarka torkdukar
- Genombrutna torkdukar
- Golvdukar och moppar
- Kräppade torkdukar
- Mikrofiberdukar
- Renrums- och sterila torkdukar
- Släta torkdukar
- Torkdukar tillsammans med desinfektionsmedel
- Tvättlappar
- Tvättlapp för konsument
-
För din bransch
För din bransch
Här hittar du rätt sortiment för just din verksamhet och behov
-
Hållbarhet
Vårt hållbarhetsarbete
Vi tar ansvar för en hållbar framtid genom innovation, kvalitet och omsorg. Här hittar du våra initiativ inom miljö, socialt ansvar och hållbara produkter.
- Beställning & rådgivning